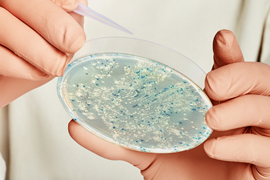
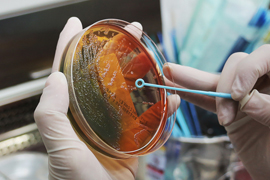

Serviços
Análise de Ar Climatizado Artificialmente
Análises de ar seguindo a Resolução – RE n° 9, de 16 de janeiro de 2003 – ANVISA e a...
VER MAISAnálise de Água Potável
Água potável é aquela que apresenta certas características que a torna adequada ao consumo humano...
VER MAISAnálise de Água de Poço
A água subterrânea é aquela existente no subsolo que passa por um processo de filtragem natural e de...
VER MAISAnálise de Água Mineral
A água mineral é aquela que possui em sua composição, propriedades físico-químicas distintas das águas...
VER MAISAnálise Microbiológica de Alimentos
As doenças transmitidas por alimentos (DTA) constituem um dos problemas de saúde pública mais freqüentes...
VER MAISAnálise Microbiológica de Manipuladores e Utensílios
Análises microbiológicas de manipuladores e utensílios seguindo a APHA e US Health....
VER MAISAnálise Microscópica e Macroscópica em Alimentos
As análises microscópicas e macroscópicas tem por objetivo o isolamento e a identificação de materiais...
VER MAISAnálise Microbiológica de Sala Limpa
Análises microbiológicas de sala limpa seguindo a Resolução RDC 17, de 16 de abril de 2010....
VER MAISConsultoria em qualidade e segurança alimentar
Consultoria em segurança alimentar com visitas periódicas no seu estabelecimento, implantação de manual...
VER MAISAlvará Sanitário
Montamos e protocolamos o seu processo de licença sanitária. Manual de Boas Práticas e Pop´s. Montamos...
VER MAISAuditoria Técnica
Seja para auto avaliação, homologação ou monitoramento de fornecedores, realizamos auditorias de forma...
VER MAISTreinamentos de acordo com as normas da Vigilância Sanitária
Programa de treinamento “In Company” ´já incluso na consultoria técnica e periódica, adequados à realidade...
VER MAIS